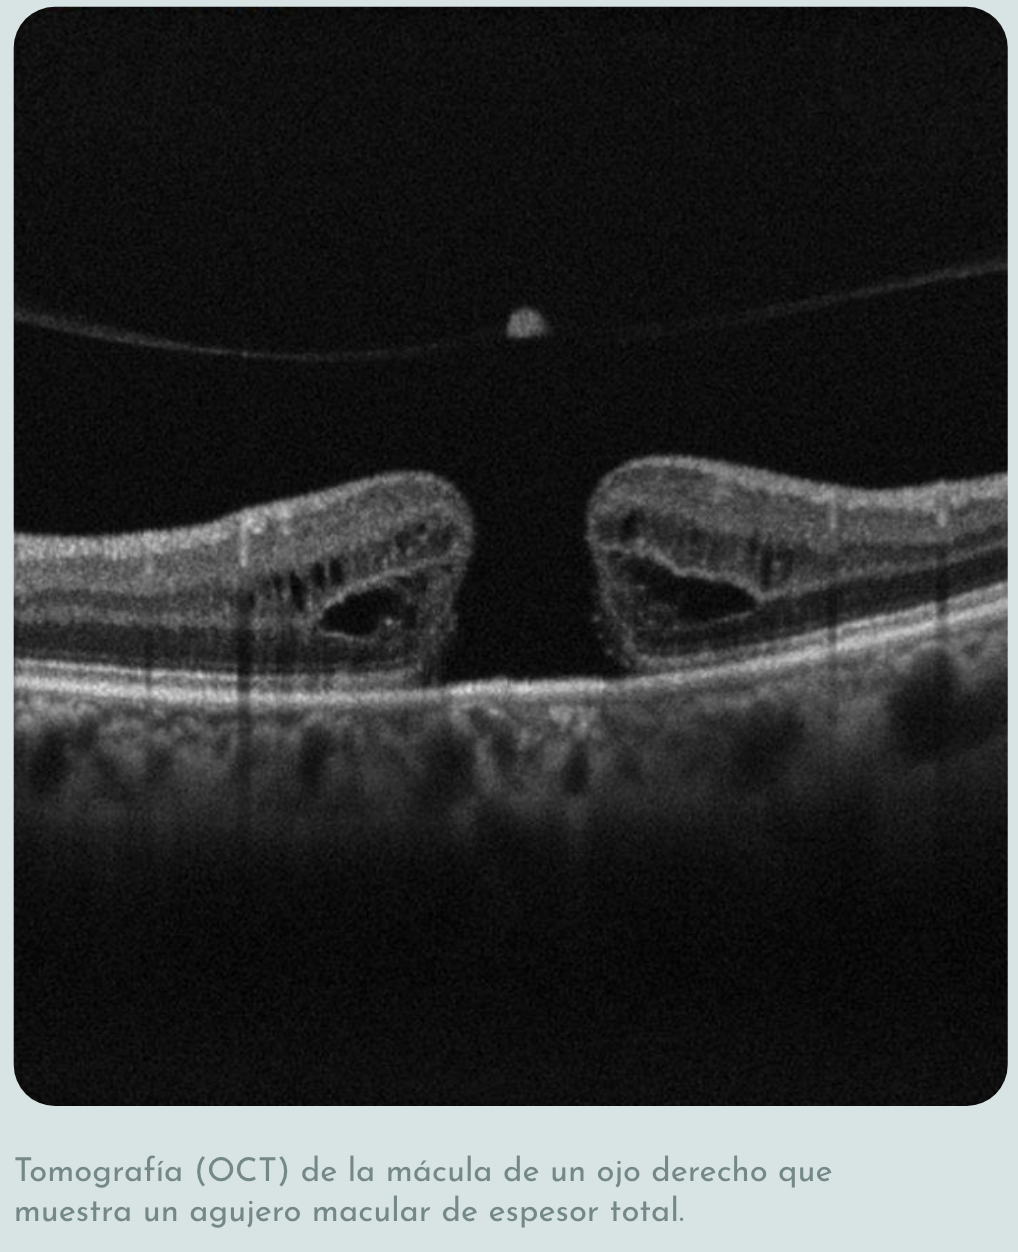

El agujero macular es una abertura o defecto que se forma en el centro de la mácula. Esta alteración afecta directamente la visión central, que es la responsable de actividades como leer, manejar o reconocer rostros.
La causa más frecuente del agujero macular es el proceso natural de envejecimiento del ojo. Durante el desprendimiento del humor vítreo, pueden generarse fuerzas de tracción sobre la mácula que provocan la formación del agujero. Con menor frecuencia, puede asociarse a traumatismos, inflamación ocular o enfermedades retinianas previas.

Los pacientes suelen notar visión borrosa en el centro del campo visual, distorsión de las imágenes y, en etapas avanzadas, la presencia de una mancha oscura central. La visión periférica generalmente se conserva normal.
El diagnóstico se realiza mediante una exploración oftalmológica. La tomografía de coherencia óptica (OCT) de la mácula es fundamental para confirmar el diagnóstico, determinar el tamaño del agujero y clasificar su etapa, lo cual es clave para decidir el tratamiento.
El tratamiento del agujero macular es quirúrgico y consiste en una vitrectomía. Durante la cirugía se retira el humor vítreo, se libera la tracción sobre la mácula y se coloca una burbuja de gas dentro del ojo para favorecer el cierre del agujero. Después de la cirugía, el paciente debe mantener una posición especial (boca abajo) durante algunos días.La probabilidad de cierre del agujero y de mejoría visual es alta, especialmente cuando se trata de manera oportuna.

Atención médica y quirúrgica de enfermedades de la retina, vítreo y cirugía de catarata, con enfoque en diagnóstico oportuno, tratamiento personalizado y tecnología de alta especialidad.
Agenda tu cita en Médica Sur